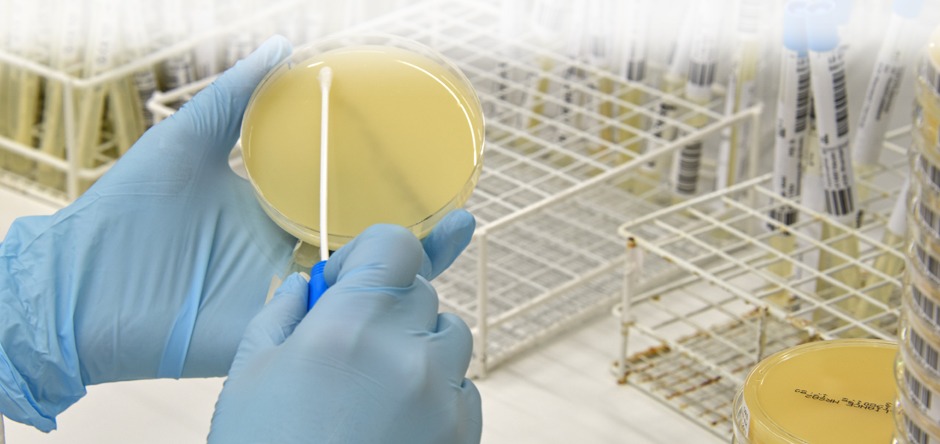

WELKOM BIJ
EUREGIO LABORATORY SERVICES
Welkom bij
Euregio Laboratory Services
Euregio Laboratory Services werd in 1994 opgericht met als doel het uitvoeren en relevante diagnostiek en het verlenen van adviezen omtrent veterinair laboratoriumonderzoek in de ruimste zin van het woord en niet beperkt tot een bepaalde diersoort. Inzending van monsters is uitsluitend mogelijk door dierenartsen of via bedrijven. Diereigenaren met diergeneeskundige vragen verwijzen wij graag naar hun eigen dierenarts…
De testen en programma’s
zijn ontwikkeld door
ELDC BV

Hieronder een aantal bestanden die u kunt downloaden
Invulformulier
Download onderstaande PDF bestand om het inzendformulier in te vullen of uit te printen.
Het inzendformulier bevat ook een goed overzicht van de prijzen.
Bestelformulier
Download onderstaande PDF om de bestellijst materialen in te vullen of uit te printen.